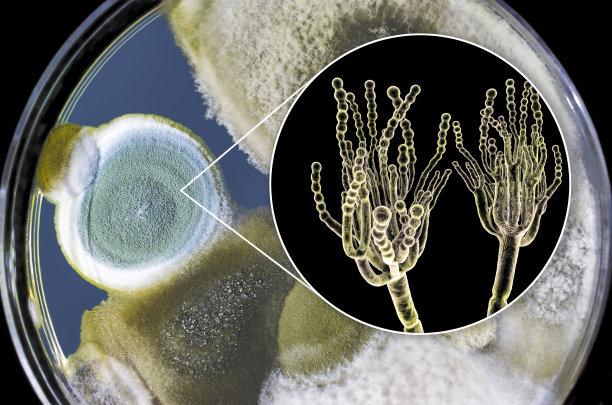

说起蘑菇....这可能是这世界最拧巴的生物。
注意啦,
这个拧巴不是形容词,而是叙述词。
没错,
我们吃的每一棵蘑菇其实都不是一个独立的个体。
而是由众多菌丝体拧巴出来的。
蘑菇主要由两部分组成。
能吃的部分叫子实体,主要用于生殖,
你理解成这是蘑菇的大根好像也没毛病。

而第二部分才是蘑菇的本体——菌丝体。
是无数根非常细长的菌丝构成,属于真菌。
要说这个真菌吧,真不复杂,
正经分也就两种,
一种是特别小的单细胞真菌,比如酵母菌,平时在微生物界嘎嘎乱杀。
另一种是奇形怪状的多细胞真菌,就是丝状真菌,比如霉菌。

蘑菇就属于丝状真菌,
这丝状真菌也有两种,
跟管子似得上下通畅的,叫无隔菌丝。
中间有隔膜的叫有隔菌丝,

甭管有隔无隔,结构方面都差不多,
负责吸收水分和养分的基内菌丝(Substrate Mycelium),
负责在空气里露脸的气生菌丝(Aerial Mycelium),
还有负责生娃的产孢结构。
再没了,简单吧?不光简单,还小,单个菌丝结构需要显微镜才能观察。
本来菌丝们凑在一起只是为了排除异己抱团取暖,
形成了肉眼可见的菌落。
偏偏以担子菌门(Basidiomycota)和子囊菌门(Ascomycota)这两大派别为代表的菌类特别有想法,再穷不能穷教育,再苦不能苦孢子,为了下一代,我们众筹个超级大根吧!!!
于是以单个菌丝为代表的初级菌丝们通过细胞质的融合形成锁状联合(clamp connection),最后组合成双核状态,这被称为次生菌丝。
听着挺复杂其实就是长一起了。

然后次生菌丝又通过高度组织化融合产生了三生菌丝,
最终聚合成一个小啾啾似的原基。

再之后时机成熟,
啵的一声,蘑菇出现了。

看着好像挺简单是吧?
不不不,从三生菌丝开始就已经朝着奇幻生物的方向发展了。
我们观察下蘑菇的结构,
除了从形态上能分出菌盖,菌柄,菌褶这三大主要结构,

部分菌类还整出了菌环,菌托等辅助结构,
另外还有鳞片,条纹等众多其他结构。
功能上除了主要的繁殖结构,还分化出了支撑结构、营养储存、防御机制、环境适应等功能。
除了这些基础功能,还衍伸出一大堆奇怪功能。
比如荧光小菇(Mycena chlorophos)可以在黑暗里发光。

比如小美牛肝菌(Boletus speciosus)误食后会看到小人。
比如草菇(Volvariella volvacea)喜欢高温,在 13~14℃以下容易自溶。
比如血齿菌(Hydnellum peckii)菌盖能渗出鲜红色液体,用于防御昆虫啃食。

狗蛇头菌(Mutinus caninus)会散发腐肉气味,吸引苍蝇传播孢子

恶魔雪茄(Chorioactis geaster)菌体裂开时形如雪茄爆炸成星形,
释放孢子时还能发出口哨声

等等,
我记得之前说这玩意是由一堆独立的菌丝组成的,
既没图纸也没规划,甚至还没脑子,这些奇幻的玩意就攒出来了?
实际上,蘑菇不光长得千奇百怪,种类也非常多。
世界上大型真菌预估有 50000 种,
中国已记录的蘑菇种类约4000 种,包括食用菌 1000 余种、毒蘑菇 435 种。[1]
食用菌单按长相就可分出 7 大类,约 30 种典型形态。

更有意思的是很多蘑菇都会有点奇怪的小脾气。
比如松茸(Tricholoma matsutake)依赖与赤松的菌根共生,
鸡枞菌(Termitomyces albuminosus)只喜欢和白蚁贴贴,
至今人工培育都很困难。
就算是普通蘑菇,也或多或少有点抖 M
在日本江户时期,
就有一本叫《惊蕈录》的吓唬蘑菇指南,
就是通过敲打木头来使得蘑菇增产。
这是由于捶打木头产生的震动会刺激菌丝扭结,让原来懒散的菌丝团冒出蘑菇。
而自然条件下,打雷也能促进蘑菇生长,
在明代的《通雅》里就有提到:
平西有断椿、榆、构,斧其皮,久雨烂之, 以米潘沃之,雷则出覃矣。不雷则大斧击之而覃亦出。
大概意思就是烂木头把皮去掉,平时用淘米水浇,打雷后就会长出蘑菇,不打雷的话用斧头敲一顿也能长。
所以说雷雨天气后蘑菇更多,这是有科学依据的。
那既然已经了解蘑菇了,咱回归下原问题:
蘑菇根上的泥再送回山上,第二天会不会长蘑菇?
答案很明显,不会。
但是环境适宜的话过一段时间还是会重新长出蘑菇。
那会长出公蘑菇还是母蘑菇呢?
咱先看母蘑菇,
比如竹荪能长出非常漂亮的白色渔网袜。

而长得像竹荪的白鬼笔(Phallus impudicus)就更了不得了。
直接整出一个形神兼备的大根。

谁家正经蘑菇长成这样啊!!!!!!

